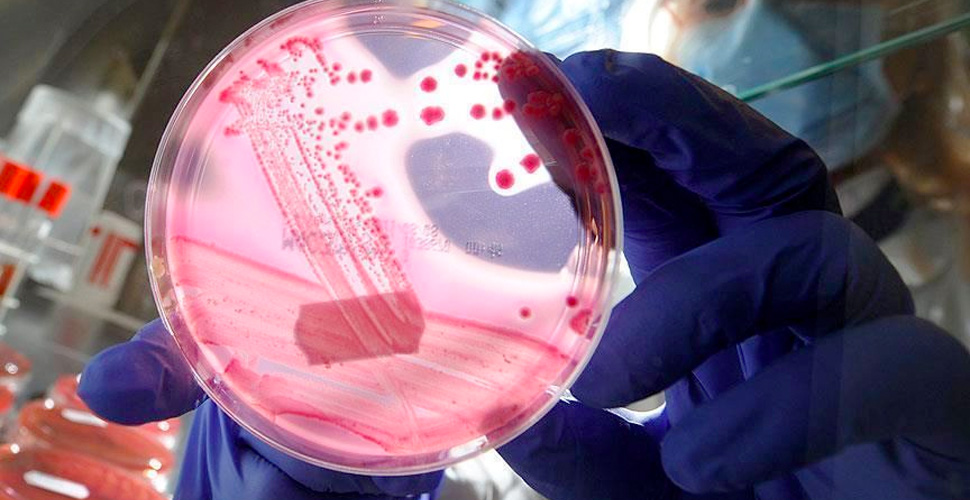
Türk bilim insanları kanserle savaşacak ''uyuyan hücrelerin'' şifrelerini keşfetti

Hacettepe Üniversitesinden Prof. Dr. Güneş Esendağlı ve ekibi tarafından bağışıklık sistemi hücreleri üzerinde yapılan çalışmada, kanser hastalarının kanında, kansere karşı savaşma kabiliyetini yitirmemiş yeni hücre belirlendi. Kanser tedavisine ışık tutacak çalışma, dünya bilim çevrelerinde de geniş yankı uyandırarak, uluslararası tıp dergilerine kapak olarak seçildi.
Kanser tedavisinde çığır açacak bir çalışmaya imza atan Prof. Dr. Esendağlı, AA muhabirine yaptığı açıklamada, bağışıklık (immün) sisteminin kanser hücrelerini yok edebildiğini, özelikle hastalığın ileri evrelerinde kanserle savaşma yeteneğini zayıflattığını, bazı bağışıklık hücrelerinin de karakter değiştirerek kanserin gelişmesine ve yayılmasına destek olmaya başladığını söyledi.
Prof. Dr. Esendağlı, kanser hastalarında bağışıklık sistemini güçlendirmek ve kansere karşı yanıtlarını yeniden canlandırmak amacıyla yeni tedavilerin geliştirildiğini belirterek, kanser hastalarının bağışıklık hücrelerindeki değişiklikleri anlamanın ve keşfetmenin büyük önem taşıdığını vurguladı.
Yapılan çalışmayla, bağışıklık hücrelerinden bazı alt tiplerin kansere karşı savaşmaya devam edebileceğine dikkati çeken Esendağlı, bahsedilen hücrenin, kanser hastalarının kan dolaşımında olan bir hücre olduğunu söyledi.
"KOLON VE MEME KANSERİ HASTALARI ÜZERİNDE ÇALIŞILDI"
Esendağlı, bağışıklık hücrelerini farklı alt gruplara ayırdıklarını ifade ederek, şu bilgileri aktardı:
"Kan dolaşımında 'monosit' adı verilen, insan vücudundaki yabancı veya artık maddeleri ortadan kaldıran, ortamdaki inflamasyon (yangı) sinyallerini yaratan ve mikroplara özel molekülleri bağışıklık sistemine sunma kapasitesine sahip bir hücre tipi mevcut. Bu monosit hücrelerinin üzerinde bazı molekülleri belirleyip bunların aslında bazı alt tiplerinde farklı olduğunu gördük. Çok geniş bir hasta grubunda çalıştık. Kalın bağırsak ve meme kanserinde bu gruba odaklanmışken bunların varlığını, artışını orada göstermişken daha sonra akciğer, pankreas gibi kanserlerde bunun varlığını doğruladık."
Esas çalışmanın kolon ve meme kanseri üzerinde gerçekleştirildiğini anlatan Esendağlı, "Yaptığımız işlemler ile bu hücrelerin farklı olduğunu, farklı moleküller taşıdığını belirledik. Monosit dediğimiz bağışıklık hücre grubuna ait bu yeni alt tipteki hücreleri, çeşitli tekniklerle topladık. Saflaştırdık, sağlıklı kişilerde göz ardı edilebilecek kadar az olduğunu gördük. Kanser hastalarında arttığını gördük." dedi.
Topladıkları kanser hastaları hücrelerini, farklı tekniklerle karakterize ettiklerini ifade eden Esendağlı, bu hücrelerin içerisinde 20 binden fazla gen ifadesinin, nasıl değiştiğini gördüklerini söyledi. Esendağlı, "Belirlediğimiz bu hücre grubu dışındaki diğer hücrelere göre nasıl farklı davrandıklarını, kanserle savaşta immün sistemi destekleyip desteklemediklerini tüp içerisinde gösterdik." diye konuştu.
Prof. Dr. Esendağlı ve ekibi tarafından yapılan çalışmada, kanser hastalarında özel bir monosit grubu olduğuna dair bulunan kanıtlar, kanser alanında uluslararası kabul gören Kanser İmmünolojisi, İmmünoterapi Dergisinin de kapağında yer aldı.
TÜBİTAK PROJE DESTEĞİ ALDI
Türkiye Bilimsel ve Teknolojik Araştırma Kurumu (TÜBİTAK) tarafından verilen proje desteği ile yürütülen çalışma, Hacettepe Üniversitesi Kanser Enstitüsü, Temel Onkoloji Ana Bilim Dalı, Sağlık Bilimleri Enstitüsü, Dahili ve Cerrahi Araştırma Ana Bilim Dalı, Tıp Fakültesi Tıbbi Genetik Ana Bilim Dalı ve Genel Cerrahi Ana Bilim Dalından ve Sağlık Bilimleri Üniversitesi Gülhane Eğitim ve Araştırma Hastanesi Genel Cerrahi Kliniğinden araştırmacıların ortaklığı ile gerçekleştirildi.